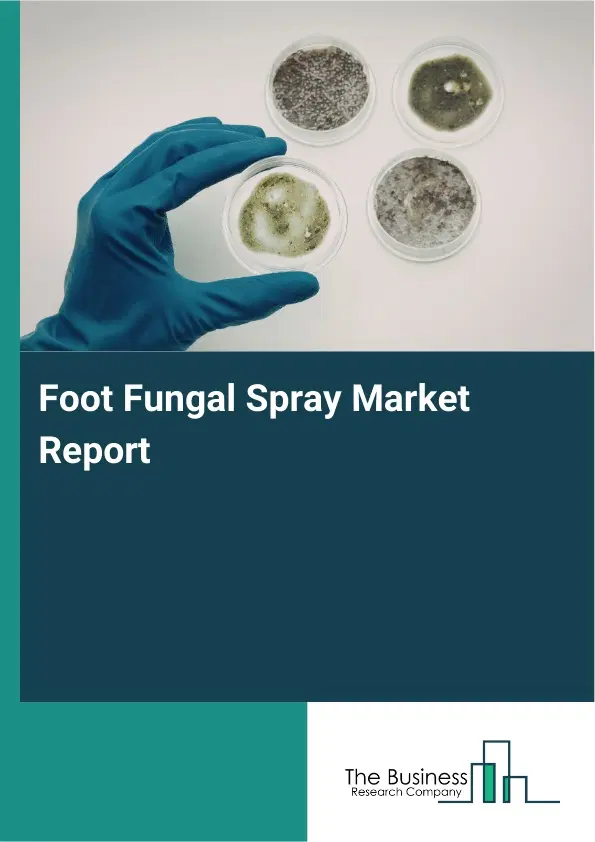
Global Foot Fungal Spray Market Report 2026

Foot Fungal Spray Market Report 2026
Global Outlook – By Product Type (Antifungal Sprays, Herbal Or Natural Sprays, Medicated Sprays, Other Product Types), By Distribution Channel (Pharmacies Or Drug Stores, Online Stores, Supermarkets Or Hypermarkets, Other Distribution Channels), By Application (Athlete’s Foot, Ringworm, Toenail Fungus, Other Applications), By End User (Adults, Children, Other End Users) – Market Size, Trends, Strategies, and Forecast to 2035
Foot Fungal Spray Market Overview
• Foot Fungal Spray market size has reached to $1.5 billion in 2025 • Expected to grow to $2.29 billion in 2030 at a compound annual growth rate (CAGR) of 8.7% • Growth Driver: Increasing Awareness Of Personal Hygiene Fueling The Market Growth Due To Rising Concern Over Fungal Infections • Market Trend: Clinically Formulated Sprays Deliver Effective Foot Care Without Prescription • North America was the largest region in 2025 and Asia-Pacific is the fastest growing region.What Is Covered Under Foot Fungal Spray Market?
Foot fungal spray is a topical solution formulated to combat and prevent fungal infections on the feet, effectively targeting the microorganisms responsible for conditions such as athlete’s foot. It soothes discomfort by reducing itching, burning, and unpleasant odors while promoting skin healing. The spray penetrates affected areas to inhibit fungal growth and prevent reinfection. Regular use supports overall foot hygiene and helps maintain healthy, resilient skin. The main product types of foot fungal sprays are antifungal sprays, herbal or natural sprays, medicated sprays, and other types. Antifungal sprays are fast-acting topical solutions that prevent and treat fungal infections on the skin, especially the feet, by stopping fungal growth and relieving discomfort. These sprays are distributed through various channels, including pharmacies or drug stores, online stores, supermarkets or hypermarkets, and other distribution channels. They are used for various applications, such as athlete’s foot, ringworm, toenail fungus, and other conditions, and are intended for different end users, including adults, children, and others.
What Is The Foot Fungal Spray Market Size and Share 2026?
The foot fungal spray market size has grown strongly in recent years. It will grow from $1.5 billion in 2025 to $1.64 billion in 2026 at a compound annual growth rate (CAGR) of 9.0%. The growth in the historic period can be attributed to increasing incidence of fungal foot infections, widespread use of communal facilities, rising awareness of foot hygiene, availability of otc antifungal treatments, growth of personal care retail channels.What Is The Foot Fungal Spray Market Growth Forecast?
The foot fungal spray market size is expected to see strong growth in the next few years. It will grow to $2.29 billion in 2030 at a compound annual growth rate (CAGR) of 8.7%. The growth in the forecast period can be attributed to increasing demand for preventive foot care solutions, rising preference for natural antifungal ingredients, expansion of e-commerce distribution channels, growing focus on skin-friendly formulations, increasing emphasis on long-term infection prevention. Major trends in the forecast period include increasing adoption of antifungal spray treatments, rising demand for over-the-counter foot care products, growing preference for herbal and natural formulations, expansion of preventive foot hygiene practices, enhanced focus on fast-absorbing spray formats.Global Foot Fungal Spray Market Segmentation
1) By Product Type: Antifungal Sprays, Herbal Or Natural Sprays, Medicated Sprays, Other Product Types 2) By Distribution Channel: Pharmacies Or Drug Stores, Online Stores, Supermarkets Or Hypermarkets, Other Distribution Channels 3) By Application: Athlete’s Foot, Ringworm, Toenail Fungus, Other Applications 4) By End User: Adults, Children, Other End Users Subsegments: 1) By Antifungal Sprays: Cream Based, Powder Based, Liquid Based, Spray Foam 2) By Herbal Or Natural Sprays: Aloe Vera, Tea Tree Oil, Neem Extract, Chamomile 3) By Medicated Sprays: Prescription Strength, Over The Counter, Antibacterial Medicated, Antiseptic Medicated 4) By Other Product Types: Cooling Sprays, Deodorizing Sprays, Moisturizing Sprays, Antiperspirant SpraysWhat Is The Driver Of The Foot Fungal Spray Market?
The increasing awareness of personal hygiene is expected to propel the growth of the foot fungal spray market going forward. Personal hygiene refers to the practices and habits that individuals adopt to maintain cleanliness and health of their body and surroundings to prevent illness and promote overall well-being. The rising awareness is primarily driven by recent health crises that have highlighted the critical role of hygiene practices in disease prevention, resulting to widespread educational campaigns and public health initiatives that emphasize proper sanitation habits. Fungal spray supports personal hygiene by effectively eliminating and preventing the growth of harmful fungi on the skin, reducing itching, odor, and discomfort, while promoting a clean and healthy environment for the feet, which helps prevent infections such as athlete’s foot and ensures overall skin well-being. For instance, in August 2025, according to the United Nations International Children's Emergency Fund (UNICEF), a US-based humanitarian aid organization, in 2024, 1.7 billion people still lacked basic hygiene services, including 611 million without any handwashing facilities, while four countries had already achieved universal access (>99%) to basic hygiene services and another nine were on track to reach it by 2030. Therefore, the increasing awareness of personal hygiene is driving the growth of the foot fungal spray industry.Key Players In The Global Foot Fungal Spray Market
Major companies operating in the foot fungal spray market are The Kroger Co., Bayer Aktiengesellschaft, Novartis AG, GSK plc, Perrigo Company plc, Prestige Consumer Healthcare Inc., Zeria Pharmaceutical Co. Ltd., The Himalaya Drug Company, Melisana Healthcare, Footlogix Inc., Hunan Huamuyang Biotechnology Co. Ltd., PediFix Inc., Kripa Pharma, Zeolite Herbals Pvt. Ltd., Marie Originals LLC, Herbax Ayurveda, Arcadia Consumer Healthcare Inc., Melisana Healthcare AG, West-Coast Pharmaceutical Works Ltd, Taisho Holdings Co. Ltd.Global Foot Fungal Spray Market Trends and Insights
Major companies operating in the foot fungal spray market are focusing on developing innovative products such as over-the-counter quasi-drugs to effectively treat fungal infections, control odor, and provide convenient, user-friendly solutions for everyday foot care. Over-the-counter quasi-drugs are products with mild medicinal effects that are approved for general use without a prescription, and they can help treat fungal infections by containing antifungal ingredients that inhibit the growth of fungi, reduce itching and redness, and promote faster healing of affected areas. For instance, in June 2025, Medi K, a South Korea-based personal hygiene company, launched Clear Solution, a medicated foot spray formulated to combat athlete’s foot and neutralize foot odor. The product comes in a convenient 200 ml spray bottle and is classified as an over-the-counter quasi-drug, allowing consumers to use it without a prescription. Clear Solution is designed for application on the soles, toes, and toenails, helping inhibit fungal growth while keeping feet fresh and odor-free. With its practical pump spray design, clinically focused formulation, and competitive pricing, the product targets active adults and athletes seeking effective, everyday foot care solutions, while also appealing to general consumers who prioritize hygiene, comfort, and convenience in maintaining healthy, odor-free feet.What Are Latest Mergers And Acquisitions In The Foot Fungal Spray Market?
In November 2023, Karo Healthcare AB, a Sweden-based consumer healthcare company, acquired the OTC brand Lamisil from Haleon UK Holdings Ltd. for USD 318.66 million (GBP 235 million). With this acquisition, Karo Healthcare AB aims to strengthen its position in the Foot Health category, expand its presence in major European markets, extend its geographical reach into new and emerging markets, and further develop the trusted Lamisil brand in collaboration with consumers, customers, and business partners to drive long-term growth. Haleon UK Holdings Ltd. is a UK-based consumer healthcare company that provides Lamisil and other OTC healthcare products.Regional Insights
North America was the largest region in the foot fungal spray market in 2025. Asia-Pacific is expected to be the fastest-growing region in the forecast period. The regions covered in this market report are Asia-Pacific, South East Asia, Western Europe, Eastern Europe, North America, South America, Middle East, Africa. The countries covered in this market report are Australia, Brazil, China, France, Germany, India, Indonesia, Japan, Taiwan, Russia, South Korea, UK, USA, Canada, Italy, Spain.What Defines the Foot Fungal Spray Market?
The foot fungal spray market consists of sales of preventive sprays, deodorizing antifungal sprays, cooling and soothing sprays, moisture-absorbing sprays, and prescription-strength sprays. Values in this market are ‘factory gate’ values, that is the value of goods sold by the manufacturers or creators of the goods, whether to other entities (including downstream manufacturers, wholesalers, distributors and retailers) or directly to end customers. The value of goods in this market includes related services sold by the creators of the goods.How is Market Value Defined and Measured?
The market value is defined as the revenues that enterprises gain from the sale of goods and/or services within the specified market and geography through sales, grants, or donations in terms of the currency (in USD unless otherwise specified). The revenues for a specified geography are consumption values that are revenues generated by organizations in the specified geography within the market, irrespective of where they are produced. It does not include revenues from resales along the supply chain, either further along the supply chain or as part of other products.What Key Data and Analysis Are Included in the Foot Fungal Spray Market Report 2026?
The foot fungal spray market research report is one of a series of new reports from The Business Research Company that provides market statistics, including industry global market size, regional shares, competitors with the market share, detailed market segments, market trends and opportunities, and any further data you may need to thrive in the foot fungal spray industry. The market research report delivers a complete perspective of everything you need, with an in-depth analysis of the current and future state of the industry.Foot Fungal Spray Market Report Forecast Analysis
| Report Attribute | Details |
|---|---|
| Market Size Value In 2026 | $1.64 billion |
| Revenue Forecast In 2035 | $2.29 billion |
| Growth Rate | CAGR of 9.0% from 2026 to 2035 |
| Base Year For Estimation | 2025 |
| Actual Estimates/Historical Data | 2020-2025 |
| Forecast Period | 2026 - 2030 - 2035 |
| Market Representation | Revenue in USD Billion and CAGR from 2026 to 2035 |
| Segments Covered | Product Type, Distribution Channel, Application, End User |
| Regional Scope | Asia-Pacific, Western Europe, Eastern Europe, North America, South America, Middle East, Africa |
| Country Scope | The countries covered in the report are Australia, Brazil, China, France, Germany, India, ... |
| Key Companies Profiled | The Kroger Co., Bayer Aktiengesellschaft, Novartis AG, GSK plc, Perrigo Company plc, Prestige Consumer Healthcare Inc., Zeria Pharmaceutical Co. Ltd., The Himalaya Drug Company, Melisana Healthcare, Footlogix Inc., Hunan Huamuyang Biotechnology Co. Ltd., PediFix Inc., Kripa Pharma, Zeolite Herbals Pvt. Ltd., Marie Originals LLC, Herbax Ayurveda, Arcadia Consumer Healthcare Inc., Melisana Healthcare AG, West-Coast Pharmaceutical Works Ltd, Taisho Holdings Co. Ltd. |
| Customization Scope | Request for Customization |
| Pricing And Purchase Options | Explore Purchase Options |